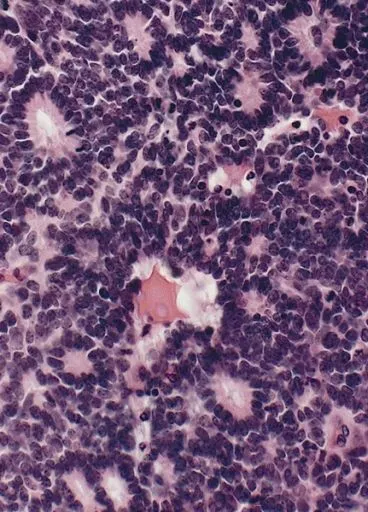
Preparat histopatologiczny retinoblastoma (siatkówczaka) z charakterystycznymi rozetkami Flexnera-Wintersteinera.

Istnieje wiele poziomów znieczulicy na cierpienie drugiego człowieka. Niektórym ludziom łatwo jest powiedzieć do staruszki przykutej do łóżka „umrzecie babko, umrzecie”. Jednak mało kto ma czelność powiedzieć to samo do dziecka, czy jego rodzica. Nawet wśród osób, którymi rządzą dawno zapomniane atawizmy pojawia się tyle empatii, aby powstrzymać się od tego typu komentarzy. Komunikacja lekarz – pacjent to ważny temat, o którym powszechnie się nie mówi. Natomiast ten artykuł będzie o patologii wieku dziecięcego, która w niektórych przypadkach kończy się dramatem. Naszym gościem jest tytułowa retinoblastoma. Nowotwór atakujący zwierciadła duszy najmłodszych.
Gen RB – zarządca genomu
Siatkówczak to niezwykle istotna choroba, na podstawie której udało się ustalić mechanizmy nowotworzenia. Badając patogenezę nowotworu udało się wyizolować gen RB (retinoblastomy). Należy on do rodziny genów supresorowych, które mają w swoim arsenale szereg sposobów, aby nie dopuścić do powstawania i rozrastania się populacji komórek, których rozplem kończy się tragicznie dla pacjenta onkologicznego. Produkt genu Rb odpowiada za punkt kontrolny między fazą G1 a S cyklu komórkowego. Jest to punkt krytyczny, którego przejście determinuje dokonanie mitozy (zwiększenie liczby komórek). Można delikatnie opóźnić ten proces, ale po pewnym czasie musi się dokonać. RB jest punktem zwornikowym ścieżek sygnalizacyjnych czynników wzrostu. Białko RB w formie aktywnej jest związane z promotorem dla genów fazy S, co uniemożliwia ich transkrypcje. Jeżeli dojdzie do inaktywacji RB to droga do przejścia kolejnych faz cyklu stoi otworem. Stałe włączenie RB będzie skutkowało rozplemem komórek nowotworowych (Weinberg R., 1995)1.
Możliwe jest inaktywowanie biała RB na innej drodze niż mutacja w obrębie genu. Tak się dzieje w przypadku HPV. Wirus ten powoduje utworzenie białka E7, które inaktywuje funkcje RB, co prowadzi do niekontrolowanego wzrostu. O HPV pisałem tutaj. Mutacja w obrębie RB jest ważnym elementem w złośliwej transformacji nowotworowej. Obok genu RB dużą rolę odkrywają czynniki jak CDKN2A, cyklina D, CDK4, które są zmutowane w większości nowotworów złośliwych u ludzi.
Zachorowanie na siatkówczaka wymaga dwóch mutacji w obrębie genu RB. Dzieje się tak ze względu na fakt, że jest to gen supresorowy, a do jego wyłączenia konieczne jest utracenie obu alleli. Osoby, które doświadczają dziedzicznej formy siatkówczaka otrzymują od rodzica uszkodzoną jedną kopię genu. Drugie uderzenie przychodzi na drodze mutacji somatycznej. Niezależnie od sposobu utraty genu Rb efekt jest ten sam – progresja nowotworowa. Obecnie udało się ustalić, że utrata genu Rb występuje również w raku piersi, raku drobnokomórkowym płuc, jak i w raku pęcherza. O tym ostatnim raku mogliście przeczytać w poprzednim artykule.
Epidemiologia
Osoby w wieku 1-19 lat najczęściej giną w wypadkach. Drugą przyczyną śmierci, a zarazem pierwszą przyczyną chorobową stanowią nowotwory. Odnotowuje się około 1000 przypadków zachorowań rocznie u dzieci (Szymborski J., et al., 2014)2.
Siatkówczak jest najczęstszym nowotworem wewnątrzgałkowym u dzieci. Zachorowalność wynosi 1:15 000 (Kobylarz J., et al., 2009)3. Nosiciele zmutowanego allelu genu RB mają 10 000 krotnie większe ryzyko na rozwój siatkówczaka niż w populacji bez mutacji. Retinoblastoma w przypadkach rodzinnych rozwija się obuocznie i wieloogniskowo. 40% rozpoznawanych siatkówczaków ma charakter rodzinny. Kolejne 60% nie jest związane z genetyką. Przebieg nowotworów jest jednooczny i jednoogniskowy, co znacznie poprawia rokowanie.
Objawy
Najczęściej rozpoznanie siatkówczaka stawia się około 2 roku życia dziecka. Pierwszym występującym objawem jest leukokoria, która pojawia się w 58% przypadków. Termin ten określany był dawniej jako refleks kociego oka – barwne sformułowanie, ale pejoratywne. Leukokoria może występować jako jedyny objaw choroby, co miało miejsce w 39,2% przebadanych osób. (Kobylarz J., et al., 2009)3. W pozostałych przypadkach dodatkowymi symptomami jest zez. Ze względu na ten fakt aktualnie każde dziecko, które cierpi na tę przypadłość musi przejść diagnostykę w kierunku siatkówczaka. Czasami retinoblastoma manifestuje się na początku w postaci jaskry, oczopląsu, czy zwykłego pogorszenia widzenia. Wymaga to czujności diagnostycznej u pediatry, aby nie przegapić ważnej choroby.

Ryc. A – opis w tekście (Kumar V., et al., 2014).
Historia naturalna
Konsekwencje odroczenia diagnostyki bywają zatrważająco smutne. Pozostawiony samemu sobie siatkówczak może pokonać granicę gałki ocznej, naciekać otaczające struktury oczodołu oraz dawać odległe przeżuty. Nieleczona retinoblastoma jest wyrokiem śmierci. Stopień zaawansowania nowotworu determinuje sposób leczenia. Jak się domyślacie po Ryc. A jednym ze sposobów leczenia jest usunięcie gałki ocznej. Dramatyczna decyzja dla rodzica, trauma dla dziecka. Jednak na enukleacji gałki ocznej można poprzestać wyłącznie wtedy, gdy patomorfolog stwierdzi brak przekroczenia struktur oka przez komórki nowotworowe. W przypadku wykrycia nacieku konieczne jest wypatroszenie oczodołu. Oznacza to usunięcie wszystkich tkanek z okostną włącznie. Stanowi to zabieg bardzo poważny, ale umożliwia wyleczenie w 95%. Konsekwencją zabiegu jest oczywisty brak tkanek, na których opiera się proteza oka. Jednak współczesna medycyna posiada techniki, które umożliwiają oszczędzenie gałki ocznej malucha. Warunkiem zastosowania lasera lub kriokoagulacji jest mały rozmiar nowotworu. Można uzyskać zmniejszenie siatkówczaka przez chemioredukcje prowadzoną przez onkologa. W przypadku niepowodzenia pozostaje radioterapia.
Patomorfologia
Retinoblastoma ma w nazwie człon „blastoma”, co sugeruje, że nowotwór wywodzi się z komórek prymitywnych. Nic bardziej mylnego. Obecnie wiadomo, że siatkówczak bezpośrednio wywodzi się z komórek nerwowych, czyli wysokozróżnicowanych. Jak widać na Ryc. A retinoblastoma tworzą masy guzowe czasami z pulą komórek satelitarnych. Jeżeli się przyjrzymy to zobaczymy komórki o hiperchromatycznych jądrach, które przypominają retinoblasty. Bardzo ciekawym znaleziskiem w obrębie nowotworu, które stanowi jedno z kryteriów rozpoznania, są rozetki Flexnera-Wintersteinera – budowane z prostopadłych komórek wokół centralnie położonego światła. Jest to o tyle ciekawe, że w nowotworach uważanych za blastyczne tradycyjnie nie spodziewamy się organizacji komórek w jakiekolwiek struktury.
Ryc. B – preparat histopatologiczny siatkówczaka z charakterystycznymi rozetkami Flexnera-Wintersteinera.
Na koniec warto podsumować parę istotnych faktów:
- Retinoblastoma jest najczęściej spotykanym nowotworem wewnątrzgałkowym u dzieci. Jednak nie jest to najczęstsza choroba nowotworowa w tej populacji. Królują białaczki, o których zamierzam się rozpisać w przyszłości.
- Badania nad genem RB nie tylko pozwoliły na ustalenie mechanizmów nowotworzenia. Tego typu naukowa dociekliwość pozwala ustalić punkty uchwytu terapii celowanych, których ideą jest uderzenie w specyficzną populacje komórek nowotworowych, tak aby ograniczyć oddziaływanie na zdrowe komórki.
- Retinoblastoma jest uleczalna, nawet bez okaleczania dziecka w przypadku wczesnego wykrycia, co jest najbardziej optymistycznym akcentem tego artykułu.
- Osoby z rodzinną wersją siatkówczaka, powinny zostać objęte poradnictwem genetycznym. Niestety w Polsce tego typu usługi są świadczone tylko przez nieliczne ośrodki, co daje efekt w postaci objęcia opieką 1/3 rodzin, które tego wymagają.
- Niestety osoby z germinalną mutacją RB mają większą podatność na zachorowanie na inne nowotwory np. osteosarcoma.
- Tutaj zostawiam stronę, na której szybko można sprawdzić trendy zachorowań na nowotwory w Polsce 6.
- Cytat „umrzecie babko, umrzecie” jest autentyczny.
za zgodą i wsparciem @hitsug
I appreciate, lead to I found just what I was having a look for.
You’ve ended my four day long hunt! God Bless you man. Have a nice day.
Bye
Thank you very much for your kind words!
I’m glad I could help and that your search ended successfully.
Wishing you all the best and a great day — good luck going forward!
I am actually glad to glance at this blog posts which consists of tons of useful facts, thanks for providing these statistics.
Thank you! I’m really glad you found the post useful. 😊
I appreciate your feedback, and I’m happy the post were helpful. Thanks for reading!
I really love your website.. Great colors & theme. Did you make
this amazing site yourself? Please reply back as I’m wanting to create my very own site
and would love to know where you got this from or
what the theme is named. Thank you!
Thank you so much for the kind words! 😊
I’m really glad you like the design. Yes, I did create the site via WP tools. If you’re planning to build your own, feel free to let me know what kind of website you’re aiming for and I’ll be happy to point you in the right direction or share some tips.
Thanks again, and good luck with your project!
I am extremely inspired along with your writing talents as well as
with the structure on your weblog. Is that this
a paid topic or did you modify it your self? Either way keep up
the nice quality writing, it’s rare to peer a great weblog like this one nowadays..
My spouse and I stumbled over here by a different web address and thought I
might as well check things out. I like what I see so now i am
following you. Look forward to finding out about your web page again.